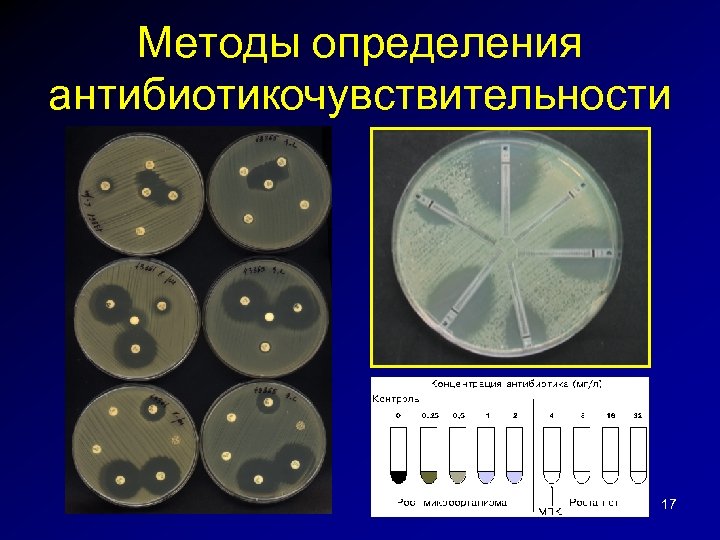
Методы определения антибиотикочувствительности 17

a8bdfd13b091cfd48605764ab2938b01.ppt
- Количество слайдов: 43

Организация и результаты микробиологического мониторинга в отделении реанимации. Опыт сотрудничества с центральной лабораторией Б. З. Белоцерковский Российский национальный исследовательский медицинский университет им. Н. И. Пирогова Кафедра анестезиологии и реаниматологии ФДПО Больница Святителя Алексия, г. Москва

Эпидемиологический надзор • микробиологический мониторинг (данные видовой идентификации возбудителей ВБИ, выделенных от пациентов, персонала, из объектов внешней среды, определение чувствительности /резистентности выделенных штаммов к антимикробным средствам: антибиотикам, антисептикам, дезинфектантам и др. ); • выявление, учет и регистрацию ВБИ у медицинского персонала; • оценка эффективности проводимых мер борьбы и профилактики. Санитарно-эпидемиологические требования к организациям, осуществляющим медицинскую деятельность, САНПи. Н 2. 1. 3. 2639 -10 2

Больница Святителя Алексия, г. Москва 3

Больница Святителя Алексия ХИРУРГИЯ 80 коек ТЕРАПИЯ 40 коек НЕВРОЛОГИЯ 60 коек ОТДЕЛЕНИЕ ПАЛЛИАТИВНОЙ ПОМОЩИ 70 коек РЕАНИМАЦИЯ 6 -9 коек

ГБУЗ «Диагностический центр (Центр лабораторных исследований) Департамента здравоохранения г. Москвы» • Заключен договор с «удаленной» лабораторией • Материал отправляем ежедневно, за исключением выходных. • Микробиологи используют автоматические бактериологические анализаторы Vitek 2, Microscan Walk Away, масс-спектрометр Microflex. 5


7

Подтверждение случаев инфекции, вызванной вирусом гриппа • ОРЗ + положительный результат по крайней мере одного теста: – ПЦР (назальные, носоглоточные образцы, мазок из зева, секрет н. д. п. ) → Управление Роспотребнадзора по г. Москве, ФБУЗ «Центр гигиены и эпидемиологии в городе Москве» (Графский пер. , 4/9) – Выделение вируса на куриных эмбрионах – 4 -х кратная динамика титра специфических АТ к АГ вируса в парных сыворотках переболевших (ретроспектива) – Иммунохроматографический экспресс-тест для качественного определения нуклеопротеиновых АТ гриппа А и В (не валидирован 8 для тяжелого гриппа!)

Этапы микробиологического исследования 1. Преаналитический – получение, хранение, транспортировка биоматериала; завершается регистрацией образца и внесением данных в ЛИС • Наши обязанности: строгое следование МУ «Техника сбора и транспортирования биоматериалов в микробиологические лаборатории» (4. 2. 2039 -05) 9

10

11

Наши пожелания • Обеспечение стационаров коммерческими средами для автоматического гемокультивирования, транспортными средами для раневого отделяемого и системами для взятия трахеобронхиального аспирата • Создание условий для хранения мочи и респираторных образцов в течение 2 -3 суток 12

Этапы микробиологического исследования 2 – аналитический • начинается с микроскопии • результаты микроскопии и сведения об идентификации клинически значимых бактерий должны быть доступны для клинициста в реальном масштабе времени. 13

Наши пожелания микробиологам • Работа 24/7 • Обязательная микроскопия респираторных образцов с подсчетом эпителиоцитов, полиморфноядерных лейкоцитов, альвеолоцитов; скрининг Гр+ и Грмикроорганизмов 14

• Определение микробной нагрузки 15

Необходимый и достаточный спектр АМП для определения чувствительности • Enterobacteriaceae – ингибиторзащищенные пенициллины, ЦIII-IV, Ц/С, КП, ФХ, АГ, тигециклин • P. aeruginosa – антисинегнойные ЦIII-IV, Ц/С, пип/тазо, антисинегнойные КП (каждый!) и ФХ, АГ, полимиксины • Acinetobacter - ЦIII-IV, Ц/С, антисинегнойные КП, ФХ, АГ, тигециклин, полимиксины • Стафилококки – оксациллин, ванкомицин, линезолид, «респираторные» ФХ, рифампицин, клиндамицин, гентамицин/нетилмицин, ко-тримоксазол, эритромицин, тигециклин, даптомицин 16
Методы определения антибиотикочувствительности 17

• Определение МПК и информирование лечащих врачей Микроорганизм Схемы терапии K. pneumoniae При МПК меропенема или дорипенема ≤ 8. 0 мкг/мл E. coli Максимальные дозы меропенема или дорипенема Acinetobacter spp. (продленная инфузия) + полимиксины или тигециклин в зависимости от чувствительности возбудителя; Цефтазидим/авибактам* При МПК меропенема или дорипенема > 8. 0 мкг/мл Полимиксины + тигециклин +/- аминогликозиды +/фосфомицин; Эртапенем + меропенем; Цефтазидим/авибактам* При отсутствии данных о значениях МПК меропенема Различные комбинации 3 -х или 4 -х антибиотиков: Карбапенем; тигециклин; полимиксины; цефоперазон/сульбактам или ампициллин/сульбактам; фосфомицин; аминогликозид Nordmann P, et al. Carbapenem resistance in Enterobacteriaceae: here is the storm! Trends Mol Med 2012; 18: 263 -72. Morrill HJ et al. Treatment options for carbapenem-resistant Enterobacteriaceae infections. Open Forum Infect Dis 2014 Rodriguez-Bano J. et al. Diagnosis and antimicrobial treatment on invasive infections due to multidrug-resistant Enterobacteriaceae. Guidelines of the Spanish Society of Infectious Diseases and Clinical Microbiology. Enferm Infecc Microbiol Clin 2015; 33(5): 337. e 1 -337. e 21. Bassetti M. et al. Preventive and therapeutic strategies in critically ill patients with highly resistant bacteria. Intensive Care Med 2015: 41: 776 -795 18

Условия эффективности лечения карбапенемами инфекций, вызванных нечувствительными штаммами • • МПК ≤ 8 (4 …… 16) Максимальная доза Продленная инфузия Комбинированная терапия Режимы, включающие карбапенемы, значительно эффективнее схем без карбапенемов Akova M. , Daikos G. L. , Tzouvelekis L. , Carmeli Y. Clin Microbiol Infect 2012; 18: 439 -448 Dubrovskaya Y, Chen TY, Scipione MR, et al. Risk factors for treatment failure of 19 polymyxin B monotherapy for carbapenem-resistant Klebsiella pneumoniae

до 2008 г. - NCCLS 20

Критерии интерпретации значений МПК для энтеробактерий S≤ I R≥ Имипенем, меропенем NCCLS 4 8 16 CLSI 1 2 4 EUCAST 2 4 -8 16 NCCLS, CLSI 16 32 64 EUCAST 8 16 32 1 2 4 0, 5 1 2 Амикацин Ципрофлоксацин NCCLS, CLSI EUCAST 21

Критерии интерпретации значений МПК для P. aeruginosa S≤ I R≥ NCCLS 4 8 16 CLSI 2 4 8 EUCAST 4 8 16 NCCLS 4 8 16 CLSI 2 4 8 EUCAST 2 4 -8 16 NCCLS, CLSI 8 16 32 EUCAST 8 - 16 Имипенем Меропенем Цефтазидим, цефепим 22

Распределение нозокомиальных штаммов Acinetobacter spp. по MПК тобрамицина C L S I 09 S I R E U C A S T 15 77 77 23 23 Больница Свт. Алексия, 2013 -2015 гг.

Распределение нозокомиальных штаммов K. pneumoniae по MПК имипенема C L S I 09 E U C A S T 15 S 48 27 I 25 46 R 27 27 Больница Свт. Алексия, 2013 -2015 гг.

Распределение нозокомиальных штаммов P. aeruginosa по MПК пиперциллина/тазобактама Требуем унификации критериев интерпретации результатов м/б исследований в соответствии с Клиническими рекомендациями «Определение чувствительности микроорганизмов к антимикробным препаратам» ! C L S I 09 S E U C A S T 15 91 51 I - - R 9 49 Больница Свт. Алексия, 2013 -2015 гг.

26

EUCAST 27

Распределение выделенных в РФ штаммов S. aureus по МПК ванкомицина, 1997 -2017 гг. (n=2335) 67, 92 28, 27 % 0, 09 0, 125 2, 18 0, 25 1, 54 0, 5 S 1 2 28

Нас не устраивает: • S. aureus МПК ванкомицина ≤ 2 − S • Частота положительного клинического ответа при поддержании высокой концентрации ванкомицина (> 15 мкг/мл) – при МПК ≤ 1 – 85% – при МПК 2 – 62% (р=0, 02) L. Hidayat et al. Arch Intern Med 2006; 166(19): 2138 -2144 29

Нас не устраивает: K. pneumoniae МПК тигециклина ≤ 2 – S Распределение нозокомиальных штаммов K. pneumoniae по MПК тигециклина E U C A S T 15 S 12 I 70 R 18 Больница Свт. Алексия, 2013 -2015 гг.

• Необходим внутренний и внешний контроль качества Дата 11. 08 12. 08 14. 08 17. 08 18. 08 Кровь Бр п-ть ТБА S. aureus P. aeruginosa S. aureus E. coli Амикацин S R Амокс/клав R R Источник Возбудитель Klebsiella pneumoniae R Ванкомицин R Гентамицин R R R Имипенем R R R Хлорамфен R Цефтазидим R R Ципрофлоксацин R R Эритромицин R 31

• Желательно наличие референтных лабораторий 32

• Субвидовое молекулярное генотипирование карбапенемрезистентных возбудителей методом ПЦР в реальном времени Число штаммов, n Вид Тип карбапенемаз Отправлены Продуцируют в НИИ АХ КП-азы Klebsiella pneumoniae 60 45 5 D (OXA-48) B (NDM) Pseudomonas aeruginosa 31 13 B (VIM) Acinetobacter baumannii 48 27 15 6 D (OXA-23) D (OXA-40) D (OXA-24/40) Больница Святителя Алексия в сотрудничестве с НИИ АХ СГМУ, 2014 -2017 гг.

β-лактамазы Сериновые Class А БЛШС (TEM, SHV) БЛРС (CTX-M) KPC Class С Хромосомные Amp. C Плазмидные Class D ОХА-23, 40, ОХА-48 АВИБАКТАМ Металло-β-лактамазы Class B NDM, VIM, IMP Азтреонам/авибактам Цефтолозан/тазобактам Тигециклин (Эравациклин) Полимиксины Фосфомицин в/в Плазомицин 34

Проекты НИИ Антимикробной Химиотерапии (СГМА) • МАРАФОН-2015: мониторинг распространенности и антибиотикорезистентности возбудителей инфекций в многопрофильных стационарах различных регионов России • АРЕХ: мониторинг распространенности грамотрицательных бактерий, продуцирующих карбапенемазы (Acinetobacter spp. , P. aeruginosa, Enterobacteriaceae, кроме Proteus spp. и Morganella spp. ) • ПЕГАС: многоцентровое исследование антимикробной резистентности клинически значимых штаммов пневмококков, гемофил, группы А 35 стрептококков и моракселл в России.

Экспресс-метод ПЦР-диагностики бактериальных и вирусных инфекций • Метод позволяет обнаружить в образце биоматериала ДНК – – MRSA C. difficile продуцентов БЛРС продуцентов карбапенемаз разных классов Стартовая терапия становится целенаправленной

Микологические исследования 37

38

Три этапа микробиологического исследования 3. Постаналитический этап – проверка достоверности полученных результатов и оценка этиологической значимости выделенных штаммов 39

Микробиологическая структура нозокомиальных инфекций в ОРИТ многопрофильного стационара (n=1500), 2007 - 2016 гг. Enterococcus spp. Staphylococcus spp. Другие Acinetobacter baumannii Грибы Proteus spp. P. aeruginosa Sten. malt. E. coli Klebsiella spp. Больница Свт. Алексия, г. Москва

Микробиологическая структура внебольничных интраабдоминальных инфекций (n=65), 2014 г. Staphylococcus spp. Enterococcus spp. Анаэробы Другие P. aeruginosa Klebsiella spp. E. coli Выделены штаммов Гр- бактерий, резистентных к ЦIIIIV, из них 9 чувствительны к амикацину, все чувствительны к карбапенемам. Проблема – энтеробактерии, продуцирующие БЛРС

Активность АМП в отношении нозокомиальных штаммов MRSA (in vitro)

Борьба с инфекцией Профилактика Оптимизация антимикробной терапии Мониторинг 43
a8bdfd13b091cfd48605764ab2938b01.ppt